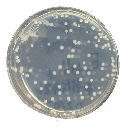
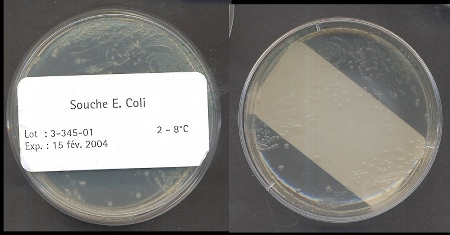

| Outre l'ensemble des produits contenus dans le
kit, les manipulations nécessitent du matériel courant de
laboratoire (bain marie, centrifugeuse, tubes Eppendorf, boîtes de
Pétri, bec bunsen, micropipettes automatiques ou pipettes Pasteur)
et doivent être menées en conditions stériles.
Après les manipulations, toutes les cultures doivent être
détruites par un traitement à l'eau de javel ou à
l'autoclave pour éviter la dispersion des bactéries dans
l'environnement.
Dès la réception du kit, les produits doivent être
stockés différemment selon leur nature : les poudres destinées
à la préparation des milieux de culture sont stockées
à température ambiante ; les cultures bactériennes
sur boîte de Pétri sont conservées au réfrigérateur
; l'ampicilline et la solution de plasmide pUC 18 sont placées au
congélateur.
|

Matériel nécessaire |
-
Préparation du matériel
et des milieux
Le matériel nécessaire doit être stérilisé
et les milieux stériles préparés préalablement
aux manipulations proprement dites.
Deux milieux différents doivent être préparés
: un milieu liquide ou bouillon (LB : Luria broth) permettant la
multiplication des bactéries receveuses et un milieu solide (LA
: Luria broth agar), similaire au précédent mais contenant
de l'agar pour le rendre solide.Une partie de ce dernier est utilisée
pour réaliser un milieu contenant de l'ampicilline destinée
à sélectionner les bactéries transformées.
Les deux milieux sont reconstitués à partir des boîtes
de poudre fournies en dissolvant respectivement 25 g de poudre LB dans
un litre d'eau distillée et 32 g de poudre LA dans un litre d'eau
distillée. Ils sont ensuite stérilisés.
L'addition de l'ampicilline au milieu LA à raison de 100 µg.mL-1
doit être faite après la stérilisation, au moment de
couler le milieu dans les boîtes de Pétri car l'ampicilline
est thermolabile.
La solution de chlorure de calcium fournie doit être diluée
au 1/10 avec de l'eau distillée avant stérilisation et répartie
dans des tubes Eppendorf à raison de 0,5 mL par tube (50 mmol.L-1).
|
-
Stérilisation du matériel
Il est possible de se procurer les petits matériels (pipettes
Pasteur, boîtes de Pétri, cônes de pipette, tubes Eppendorf)
déjà stérilisés et conservés dans un
emballage stérile. Dans ce cas, n'ouvrir les emballages que dans
la zone stérile à proximité du bec Bunsen.
Les milieux LB et LA ainsi que le petit matériel (pipettes
Pasteur, boîtes de Pétri, cônes de pipette, tubes Eppendorf,
solution de chlorure de calcium, eau distillée) peuvent être
stérilisés à l'autoclave ou, à défaut,
à la cocotte minute. Dans ce cas, mettre un peu d'eau au fond de
la cocotte (sur 2 cm de hauteur) et placer dans le panier destiné
à la cuisson à la vapeur le petit matériel enveloppé
dans du papier d'aluminium et les flacons. Attendre 20 minutes après
la mise en rotation de la soupape.
Les flacons et les paquets de papier d'aluminium contenant le petit
matériel sont ensuite disposés à proximité
du bec Bunsen et doivent être ouverts dans la zone stérile
autour de la flamme.
|
-
Répartition des solutions
Attendre le refroidissement des solutions jusqu'à ce que les
flacons puissent être manipulés sans se brûler avant
de les répartir dans les récipients appropriés :
-
Le milieu LB stérile est réparti dans des tubes Eppendorf
stériles à raison de 1 mL par tube.
-
Du milieu LA sans ampicilline est coulé dans des boîtes de
Pétri stériles (6 mL de milieu pour une boîte de 6
cm de diamètre).
-
Du milieu LA est d'abord additionné d'ampicilline à raison
de 1 mL d'ampicilline pour 200 mL de milieu avant d'être coulé
dans des boîtes de Pétri stériles (6 mL pour une boîte
de 6 cm de diamètre ).
-
La solution de chlorure de calcium à 50 mmol.L-1 est
répartie dans des tubes Eppendorf stériles à raison
de 0,5 mL par tube.
-
La solution de plasmide pUC 18 est répartie dans des tubes Eppendorf
stériles à raison de 15 µL par tube.
|
-
Culture des bactérie receveuses
Les bactéries receveuses sont fournies sous forme de colonies
sur boîtes de milieu solide :

Colonies de colibacille sur boîte de Pétri
Elles doivent être mises en culture dans le bouillon LB avant
d'entreprendre leur transformation.
Pour cela, prélever stérilement quelques colonies avec
un ensemenceur ou un cure-dents stérile et les placer dans un tube
stérile de bouillon LB.
Agiter le tube sur vortex et incuber 24 h à 37°C (48 h à
température ambiante). La multiplication des bactéries se
traduit par l'apparition d'un trouble dans le milieu comme on peut le voir
sur le cliché ci-dessous.
|

Culture de colibacilles en milieu liquide
La suspension de bactéries est ensuite répartie dans des
tubes Eppendorf stériles à raison de 1 mL de suspension par
tube.
|
-
Protocole de transformation
-
Pour réaliser la transformation proprement dite, réunir :
-
2 tubes contenant 1 mL de culture bactérienne. Marquer les tubes
par "pUC+" et "pUC-" respectivement.
-
1 tube contenant de l'eau distillée stérile
-
1 tube contenant 0,5 mL de la solution de chlorure de calcium
-
1 tube contenant 15 µL de la solution de plasmide pUC 18 (2,5 ng.µL-1)
-
2 boîtes de Pétri avec milieu solide LA sans ampicilline
-
2 boîtes de Pétri avec milieu solide LA additionné
d'ampicilline (100 µg.mL-1)
-
Bac de glace pilée
-
Bain marie à 42°C
-
1 râteau réalisé en pliant à la flamme l'extrémité
d'une pipette Pasteur boutonnée comme on peut le voir sur le cliché
ci-dessous. Bien que la notice du kit préconise d'utiliser des
billes de verre (fournies) pour étaler les bactéries, le
rateau s'avère plus efficace pour cet usage.
|

Râteau pour l'étalement des bactéries
|
|
|
Objectif des opérations réalisées
|
| 1. Centrifuger les deux tubes pUC+ et pUC- à
3 500 tours/minute pendant 3 minutes et éliminer le surnageant. |
Récupération des bactéries
en suspension. |
2. Ajouter 200 µL de solution de chlorure
de calcium et 10 µL de la solution de plasmide au tube pUC+.
3. Ajouter 200 µL de solution de chlorure de calcium et 10 µL
d'eau stérile au tube pUC-. |
Le calcium fragilise les enveloppes bactériennes
facilitant ainsi la pénétration du plasmide.
Témoin négatif. |
4. Remettre en suspension les deux culots en
agitant sur vortex et placer les deux tubes dans la glace pendant 10 minutes.
5. Placer les deux tubes au bain marie à 42°C pendant 90
secondes.
6. Remettre les deux tubes dans la glace pendant 10 minutes. |
Choc thermique. |
| 7. Ajouter 400 µL de bouillon LB dans chacun
des tubes. |
Milieu nutritif pour faire pousser les bactéries. |
| 8. Déposer 100 µL (ou 3 gouttes)
du tube pUC+ au centre d'une boîte avec ampicilline et 100 µL
au centre d'une boîte sans ampicilline. |
Permet de mesurer l'efficacité de la transformation
en comparant le nombre de colonies dans les deux boîtes. |
| 9. Déposer 100 µL du tube pUC- au
centre d'une boîte avec ampicilline et 100 µL au centre d'une
boîte sans ampicilline. |
Témoins non transformés. |
| 10. Utiliser le râteau (passé à
la flamme puis refroidi) pour étaler les bactéries à
la surface du milieu dans chaque boîte. Veiller à bien stériliser
le râteau entre deux étalements. |
Répartition des bactéries sur toute
la surface du milieu. |
| 11. Incuber les boîtes à 37°C
pendant 24 à 48 h en les plaçant couvercle vers le bas. |
Croissance des bactéries. Le retournement
des boîtes empêche l'eau de condensation de se déposer
sur les cultures.
|
-
Résultats
Dans les boîtes contenant de l'ampicilline, seules les bactéries
ayant intégré le plasmide portant le gène de résistance
à l'ampicilline sont capables de pousser. Comme un petit nombre
seulement de cellules sont transformées, on observe un petit nombre
de colonies seulement.
Dans les boîtes ne contenant pas d'ampicilline, toutes les bactéries
poussent. Comme elles sont très nombreuses, les colonies deviennent
confluentes et forment un tapis continu ("gazon") à la surface du
milieu.
|

Quelques colonies de bactéries résistantes
(donc transformées : milieu avec ampicilline)
|

Tapis de bactéries transformées ou non
(milieu sans ampicilline)
|
|
|
|
École de lADN
Muséum de Nîmes
19, Grand-rue BP 81295
30015 Nîmes Cedex 1
Téléphone : 04 66 67 82 29 |